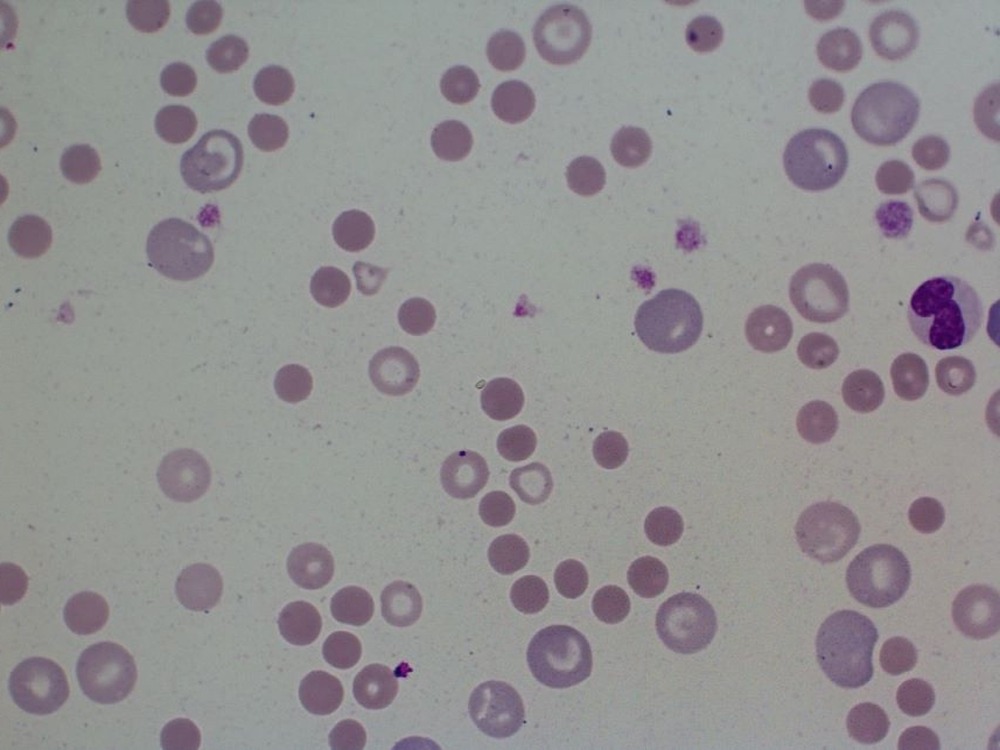
Owner looking at a dog resting at home
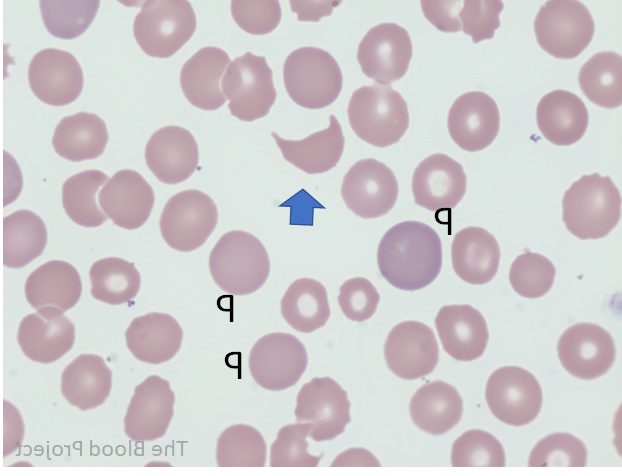

You do not usually hear the word “polycythaemia” until you notice something small that does not quite fit. A dog who normally keeps up on walks starts lagging behind, seems oddly quiet after only gentle exercise, or has gums that look more brick red than the usual healthy pink. Sometimes the first clue is a faint wobbliness, an unexpected nosebleed, or a dog who seems to drink and wee more than before.
It is easy to assume this sort of change is just age, weather, or a temporary off day. But in some dogs, these signs can be linked to blood that has become unusually concentrated, which changes how easily it flows through tiny vessels. That is where polycythaemia matters in practice, because it is less about a single diagnosis and more about what is driving the high red cell level, and whether your dog is at risk of “hyperviscosity” complications.
With the right testing, vets can usually sort out whether the problem is dehydration and haemoconcentration, or a true increase in red blood cell production. Treatment can be straightforward in some cases, and more involved in others, but the earlier the pattern is recognised, the easier it is to manage comfortably.
Understanding polycythaemia (erythrocytosis) in dogs

In dogs, “polycythaemia” is commonly used to mean erythrocytosis, an increase in circulating red blood cells. Technically, “polycythaemia” can imply increases in other blood cell lines as well, but in everyday veterinary use it often points to a raised packed cell volume (PCV), haematocrit, haemoglobin, and red blood cell count. When the red cell proportion is too high, blood can become more viscous and flow less freely through the smallest vessels, which is why some dogs develop neurological signs, bleeding tendencies, or exercise intolerance.1, 2
It is also worth holding one breed-related nuance in mind. Some sighthounds (including many Greyhounds) can have naturally higher PCV values than other dogs, so results are best interpreted against breed-appropriate context, not just a generic “normal range”.2
Relative, transient, and absolute polycythaemia
Vets generally describe erythrocytosis as relative (including transient forms) or absolute:
- Relative erythrocytosis means the plasma (fluid) portion of blood is reduced, so red cells look high in proportion. The most common reason is dehydration (for example, from vomiting, diarrhoea, heat exposure, or poor water intake).1, 2
- Transient erythrocytosis can happen when fear or excitement triggers splenic contraction and a temporary release of stored red cells into circulation. This tends to settle once the dog is calm, and repeat testing can help clarify it.2
- Absolute erythrocytosis means total red cell mass is truly increased because the body is producing more red cells than it should (or needs to). This is where the investigation shifts to primary versus secondary causes.1
Causes, what might be going on underneath

When a PCV is high, the most useful question is not “Is this polycythaemia?”, but why is it high. Broadly, causes fall into relative (dehydration, haemoconcentration), primary bone marrow disease, or secondary drivers that increase erythropoietin (EPO) or otherwise stimulate red blood cell production.1, 2
Relative erythrocytosis (haemoconcentration)
Dehydration is the classic cause, and it can happen for very ordinary reasons such as gastrointestinal upset, reduced drinking, or hot weather. In these cases, treatment focuses on rehydration and addressing the underlying trigger, and the PCV typically moves back towards normal as hydration is restored.1, 2
Primary erythrocytosis (polycythaemia vera)
Primary erythrocytosis, often called polycythaemia vera, is a myeloproliferative disorder where the bone marrow produces red blood cells autonomously. It is considered uncommon in dogs. In many cases, EPO is low or low-normal because the body is not trying to compensate for low oxygen, the marrow is simply overproducing.1
Secondary erythrocytosis (appropriate and inappropriate)
Secondary erythrocytosis is more common than primary and usually reflects an underlying driver:
- Appropriate secondary erythrocytosis occurs when the body is responding to chronic low oxygen (hypoxia), such as severe pulmonary disease or certain congenital heart defects that reduce effective oxygenation. The increased red cells are a compensatory attempt to carry more oxygen, even though it can create viscosity problems.1
- Inappropriate secondary erythrocytosis happens when EPO production is increased without systemic hypoxia, for example with EPO-secreting tumours (often renal) or some kidney disorders that create local renal hypoxia and EPO release.1
- Endocrinopathy-associated erythrocytosis can be seen with hormonal diseases where non-EPO hormones stimulate erythropoiesis (examples include cortisol, testosterone, thyroxine, growth hormone). In dogs, the increase is often mild, and may not be enough on its own to cause obvious signs, but it can add complexity to interpretation.1
Symptoms you might notice at home
Some dogs with high PCV seem fine at first, and the issue is found on routine bloodwork. Others develop signs related to poor flow and oxygen delivery at the tissue level. Common patterns include reduced stamina, weakness, and behavioural or neurological changes (for example, seeming disoriented, less coordinated, or having episodes that raise concern for seizures). Some dogs have redder mucous membranes, and some show bleeding tendencies such as nosebleeds.2
It can also look like a dehydration story, particularly if vomiting, diarrhoea, heavy panting, reduced appetite, dry or sticky gums, or sunken-looking eyes are part of the picture. These signs do not confirm polycythaemia on their own, but they are useful context for your vet, because dehydration can mimic erythrocytosis on a blood test.1, 3
If you see collapse, marked weakness, breathing difficulty, or repeated nosebleeds, it is sensible to treat it as urgent. Those signs can have several causes, but they warrant prompt veterinary assessment.
How vets confirm the diagnosis
A diagnosis starts with history and a physical exam, then moves quickly to bloodwork. A PCV, haematocrit, and a full blood count help confirm whether red cells are genuinely high, and repeated testing can be important if stress, dehydration, or a transient splenic response is suspected.2
From there, the work is often about careful sorting:
- Is this consistent with dehydration or haemoconcentration (for example, tacky mucous membranes, prolonged skin tent, or a recent history of vomiting and diarrhoea)?1
- Is there evidence of hypoxia that could be driving appropriate secondary erythrocytosis (cardiac or pulmonary disease)?1
- Is there any suggestion of renal disease or an EPO-producing mass that might cause inappropriate secondary erythrocytosis (often assessed with imaging such as abdominal ultrasound, and sometimes more advanced imaging)?1
In many patients, primary erythrocytosis is a diagnosis reached by excluding secondary causes, alongside patterns such as very high PCV and low or low-normal EPO. Your vet will interpret results in the context of breed, hydration, and concurrent disease.1
Treatment options, what management can look like

Treatment depends on the category of erythrocytosis and how symptomatic the dog is. Some dogs simply need fluid therapy for dehydration and treatment of the underlying illness that caused it. Others need a plan for longer-term control of red cell mass and viscosity risk.1, 2
Rehydration and treating the underlying cause (relative erythrocytosis)
If dehydration is driving a high PCV, management typically involves rehydration (sometimes intravenous fluids) and addressing the trigger (for example, gastrointestinal disease). The aim is to correct plasma volume and confirm that the red cell elevation resolves as hydration normalises.1, 2
Phlebotomy (therapeutic blood removal)
For primary polycythaemia vera, and sometimes for symptomatic secondary erythrocytosis, phlebotomy may be used to reduce PCV and relieve hyperviscosity signs. In primary erythrocytosis, guidance commonly describes removing a calculated blood volume (often in the range of 10 to 20 mL/kg initially) with simultaneous fluid replacement, aiming to bring PCV down to a safer range (often around 50 to 60 percent, depending on the case).1
In some cases of appropriate secondary erythrocytosis (where red cells are a response to chronic hypoxia), phlebotomy may still be used judiciously for symptom relief, but the PCV is generally maintained above normal because the underlying oxygen problem persists and the red cells are doing compensatory work.1
Hydroxyurea and other longer-term control
When ongoing control is needed, vets may prescribe hydroxyurea (an antineoplastic medication used extra-label in veterinary medicine) to suppress excessive red cell production. Dosing and monitoring are tailored to the individual, and blood counts are monitored to reduce the risk of suppressing white cells or platelets too far.1, 4
Addressing secondary drivers
If the erythrocytosis is secondary, the most meaningful treatment is often treating the underlying disease. That might mean managing severe respiratory disease, investigating and addressing cardiac shunts, or pursuing work-up and treatment for renal disease or EPO-producing tumours (which may involve surgery, oncology care, or other targeted therapies).1
Prognosis and quality of life

Prognosis is mainly shaped by the cause. Relative erythrocytosis due to dehydration often improves quickly once fluids and the underlying problem are addressed. Secondary erythrocytosis can improve if the driver is treatable, but may require ongoing management if hypoxia is chronic or if a tumour or renal condition cannot be fully resolved.1, 2
With primary polycythaemia vera, dogs may do well for extended periods with a practical routine of monitoring, periodic phlebotomy, and medication when needed. The main goal is to minimise hyperviscosity signs while keeping treatment side effects low and the dog feeling steady day to day.1, 4
Owners often find it helpful to keep notes on energy levels, thirst and urination patterns, and any episodes of wobbliness, collapse, or nosebleeds, then bring those observations to recheck appointments. It is not about watching for disaster. It is about noticing small shifts early, when adjustments are easier.
Ongoing care, what helps in everyday life
There is no single home routine that prevents polycythaemia, because many causes sit outside an owner’s control. But good general care reduces the chance that a simple dehydration episode clouds the picture, and it supports dogs who are being managed long term.
- Keep water intake easy, especially in hot weather or after exercise, and seek advice early if vomiting or diarrhoea is ongoing.3
- Attend scheduled rechecks, even when your dog seems well, because trends in PCV and blood counts guide safe adjustments to phlebotomy or medications.1
- Match exercise to capacity, aiming for consistent, moderate activity rather than sudden bursts that leave your dog flat.
- Ask your vet what signs should trigger an earlier review for your particular dog, since the most relevant red flags differ between dehydration-driven cases, hypoxia-driven cases, and polycythaemia vera.
References
- Merck Veterinary Manual: Erythrocytosis (Polycythemia) in Animals
- Merck Veterinary Manual (Dog Owners): Erythrocytosis and Polycythemia in Dogs
- Animal Welfare League Australia: Your guide to pet first aid (signs of dehydration)
- VCA Animal Hospitals: Polycythemia Vera
- Merck Veterinary Manual: Clinical Hematology (interpretation of high PCV, relative vs absolute)
- Journal of Veterinary Internal Medicine (PubMed): ACVIM consensus statement on pulmonary hypertension in dogs (hypoxia-related disease context)
- American College of Veterinary Internal Medicine (ACVIM): Consensus Statements
- Journal of Veterinary Internal Medicine: ACVIM consensus statement on the treatment of immune thrombocytopenia in dogs and cats (example of consensus process and evidence-based guidance)